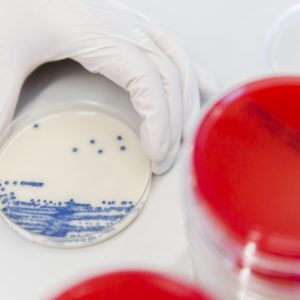

Medizinisches Know How & Service
Gelsenkirchen – Iserlohn – Siegen – Dortmund
Eurofins GeLaMed ist Ihr medizinisches Labor für Spezialanalytik und Diagnostik – wir verstehen uns als Ihr Innovationspartner im Gesundheitswesen. Unter der Leitung von Fachärzten bearbeiten wir Ihre diagnostischen Tests und eine schnelle Befundübermittlung. Zuverlässige Labordiagnostik von Eurofins GeLaMed: Dank der Kompetenz und der hochwertigen Ausstattung unserer medizinischen Labore können wir Ihnen ein breites Leistungsspektrum über 11 medizinische Fachabteilungen anbieten.
Fachabteilungen
Fachliche Kompetenz an vier Standorten
GeLaMed – Ihr medizinisches Labor
Legen Sie die Analyse Ihrer Werte in die vertrauensvollen Hände unserer Fachexperten und Laborärzte. Mit fachlicher Kompetenz an vier Standorten in ganz Deutschland und mehr als 2.000 verschiedenen Analysen aus dem Bereich der Laboratoriumsmedizin ermitteln wir schnell und zuverlässig Ihre Werte. Dabei decken wir mit unserem breiten Leistungsspektrum fortschrittliche und moderne diagnostische Möglichkeiten in der Humangenetik, medizinischen Mikrobiologie, Labormedizin und molekularen Diagnostik ab. Eurofins GeLaMed bietet Ihnen eine große Auswahl an Serviceleistungen über die klassische Labormedizin hinaus.